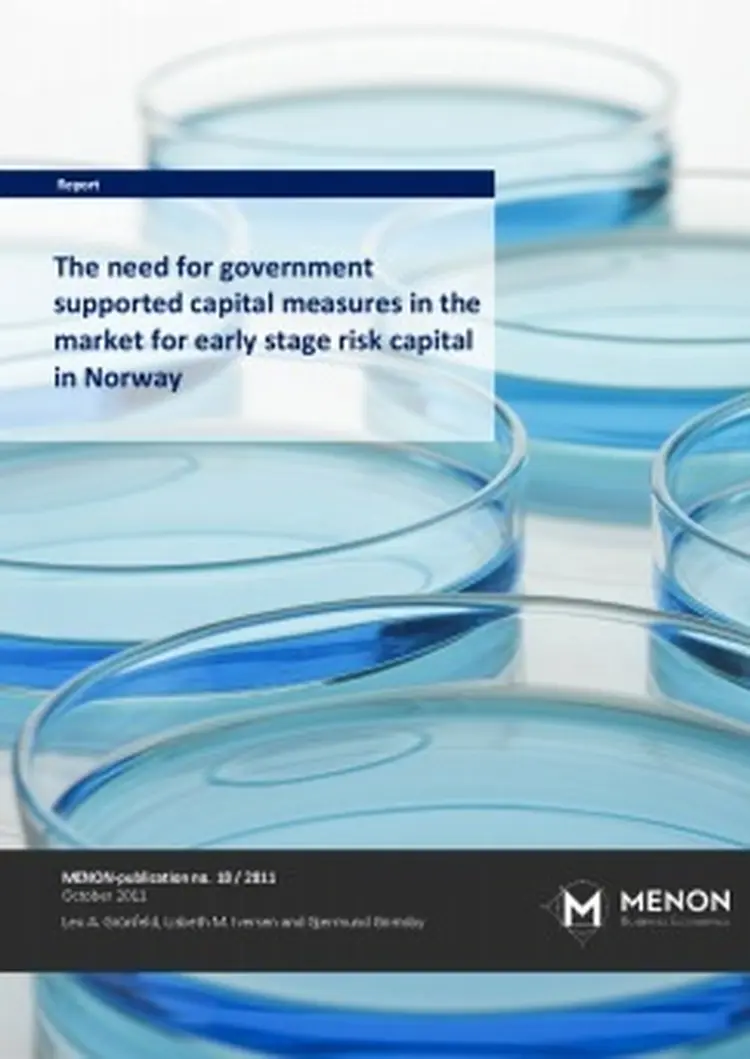
Tidligfasekapital rapport nhdv3 243x343

Report
Early stage funding in Norway: Is there a need for government supported capital measures?
Report
This report contains a study of the need for government supported capital measures in the marked for early stage project funding in Norway, also termed risk capital market. The study is conducted on behalf of the Norwegian Ministry of Trade and Industry by MENON Business Economics. It is based on a large empirical material covering the population of early stage firms in Norway and private and public suppliers of risk capital.
Other projects
Report
US Companies in Norway. Investments & Activities
Report